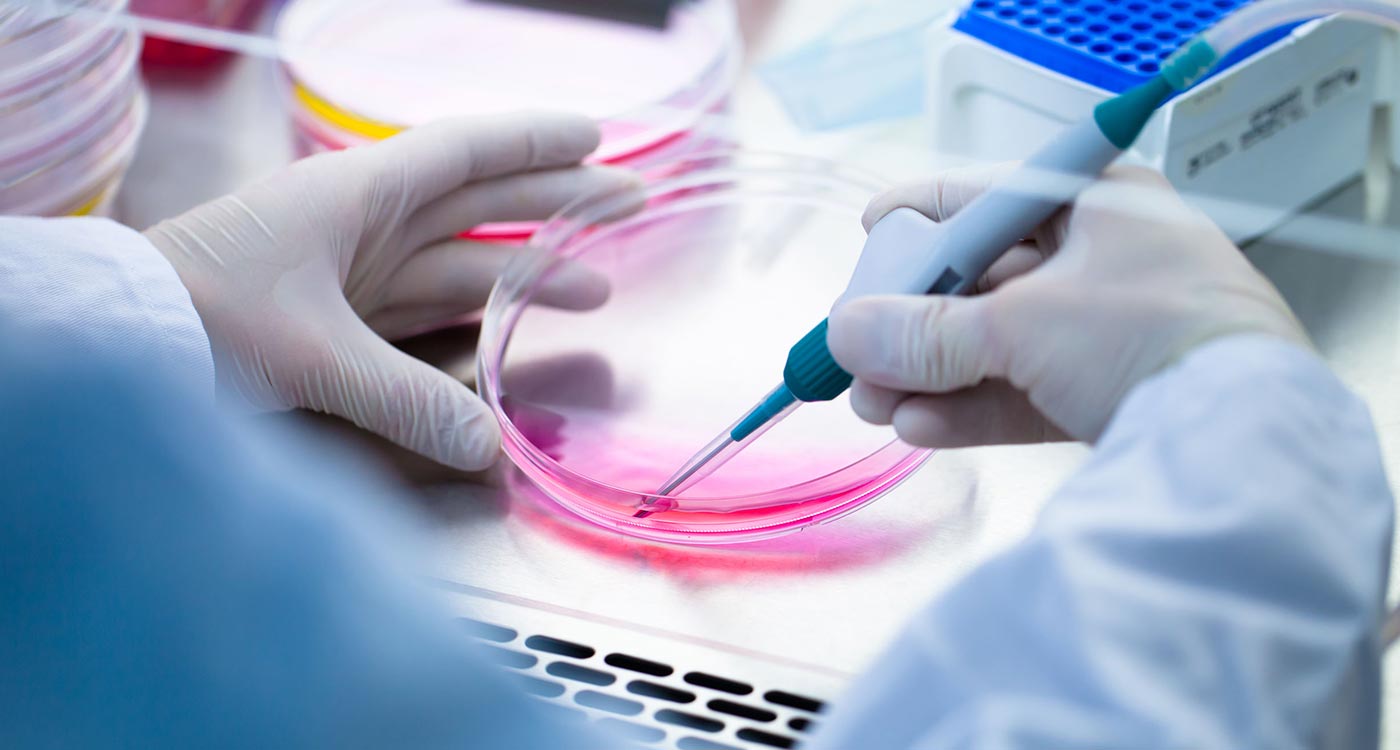
Muestra medica en Sanmiguel Health.

In the rapidly advancing field of healthcare, regenerative medicine has emerged as a groundbreaking discipline, with stem cells at the forefront of this transformation. This blog delves into the fascinating world of regenerative medicine and explores how stem cells are revolutionizing treatment options and improving patient outcomes.

Understanding Stem Cells: The Building Blocks of Regeneration
Stem cells are unique cells with the remarkable ability to develop into various types of specialized cells in the body. Their versatility makes them crucial in regenerative medicine, where they are used to repair or replace damaged tissues and organs. There are two main types of stem cells: embryonic stem cells, which can develop into any cell type, and adult stem cells, which are limited to specific lineages. This ability to differentiate into specialized cells is what makes stem cells such a powerful tool in medical treatment.
Applications of Stem Cells in Modern Medicine
The potential applications of stem cells in healthcare are vast and varied. They are already being utilized in several fields, including orthopedics, cardiology, and neurology, to treat conditions such as joint injuries, heart disease, and neurodegenerative disorders. For instance, in orthopedics, stem cells can be harvested from the patient’s bone marrow and injected into damaged joints, promoting healing and reducing pain. Similarly, research is ongoing into the use of stem cells for repairing heart tissue after a heart attack, offering hope to patients with heart disease.
The Process of Stem Cell Therapy
Stem cell therapy typically involves three key steps: harvesting, processing, and injecting the stem cells. The harvesting process usually involves a simple procedure where stem cells are collected from the patient’s own body, minimizing the risk of rejection. Once harvested, the cells are processed to concentrate and purify them before being reintroduced into the targeted area of the body. This minimally invasive approach not only reduces recovery time but also enhances the body’s natural healing capabilities.
Overcoming Challenges in Stem Cell Research
Despite the promising potential of stem cells, challenges remain in their widespread application. Ethical concerns, particularly regarding the use of embryonic stem cells, continue to spark debate within the scientific community and the public. Additionally, research is ongoing to understand the long-term effects of stem cell therapies and to ensure their safety and efficacy. As scientists work to overcome these hurdles, advancements in technology and methodology are paving the way for more effective treatments.
The Future of Regenerative Medicine
The future of regenerative medicine looks bright, with stem cells leading the charge. As research continues to uncover new applications and refine existing techniques, we can expect to see a growing integration of stem cell therapies into mainstream healthcare. This innovative approach not only holds the promise of treating previously untreatable conditions but also offers a potential shift towards more personalized and effective medical care.
Embracing the Power of Regeneration
In summary, the rise of regenerative medicine and the pivotal role of stem cells signify a transformative era in healthcare. By harnessing the power of regeneration, we can look forward to innovative treatments that enhance healing, improve patient outcomes, and ultimately redefine our approach to medicine. As this field continues to evolve, the possibilities for patient care and recovery are truly limitless.